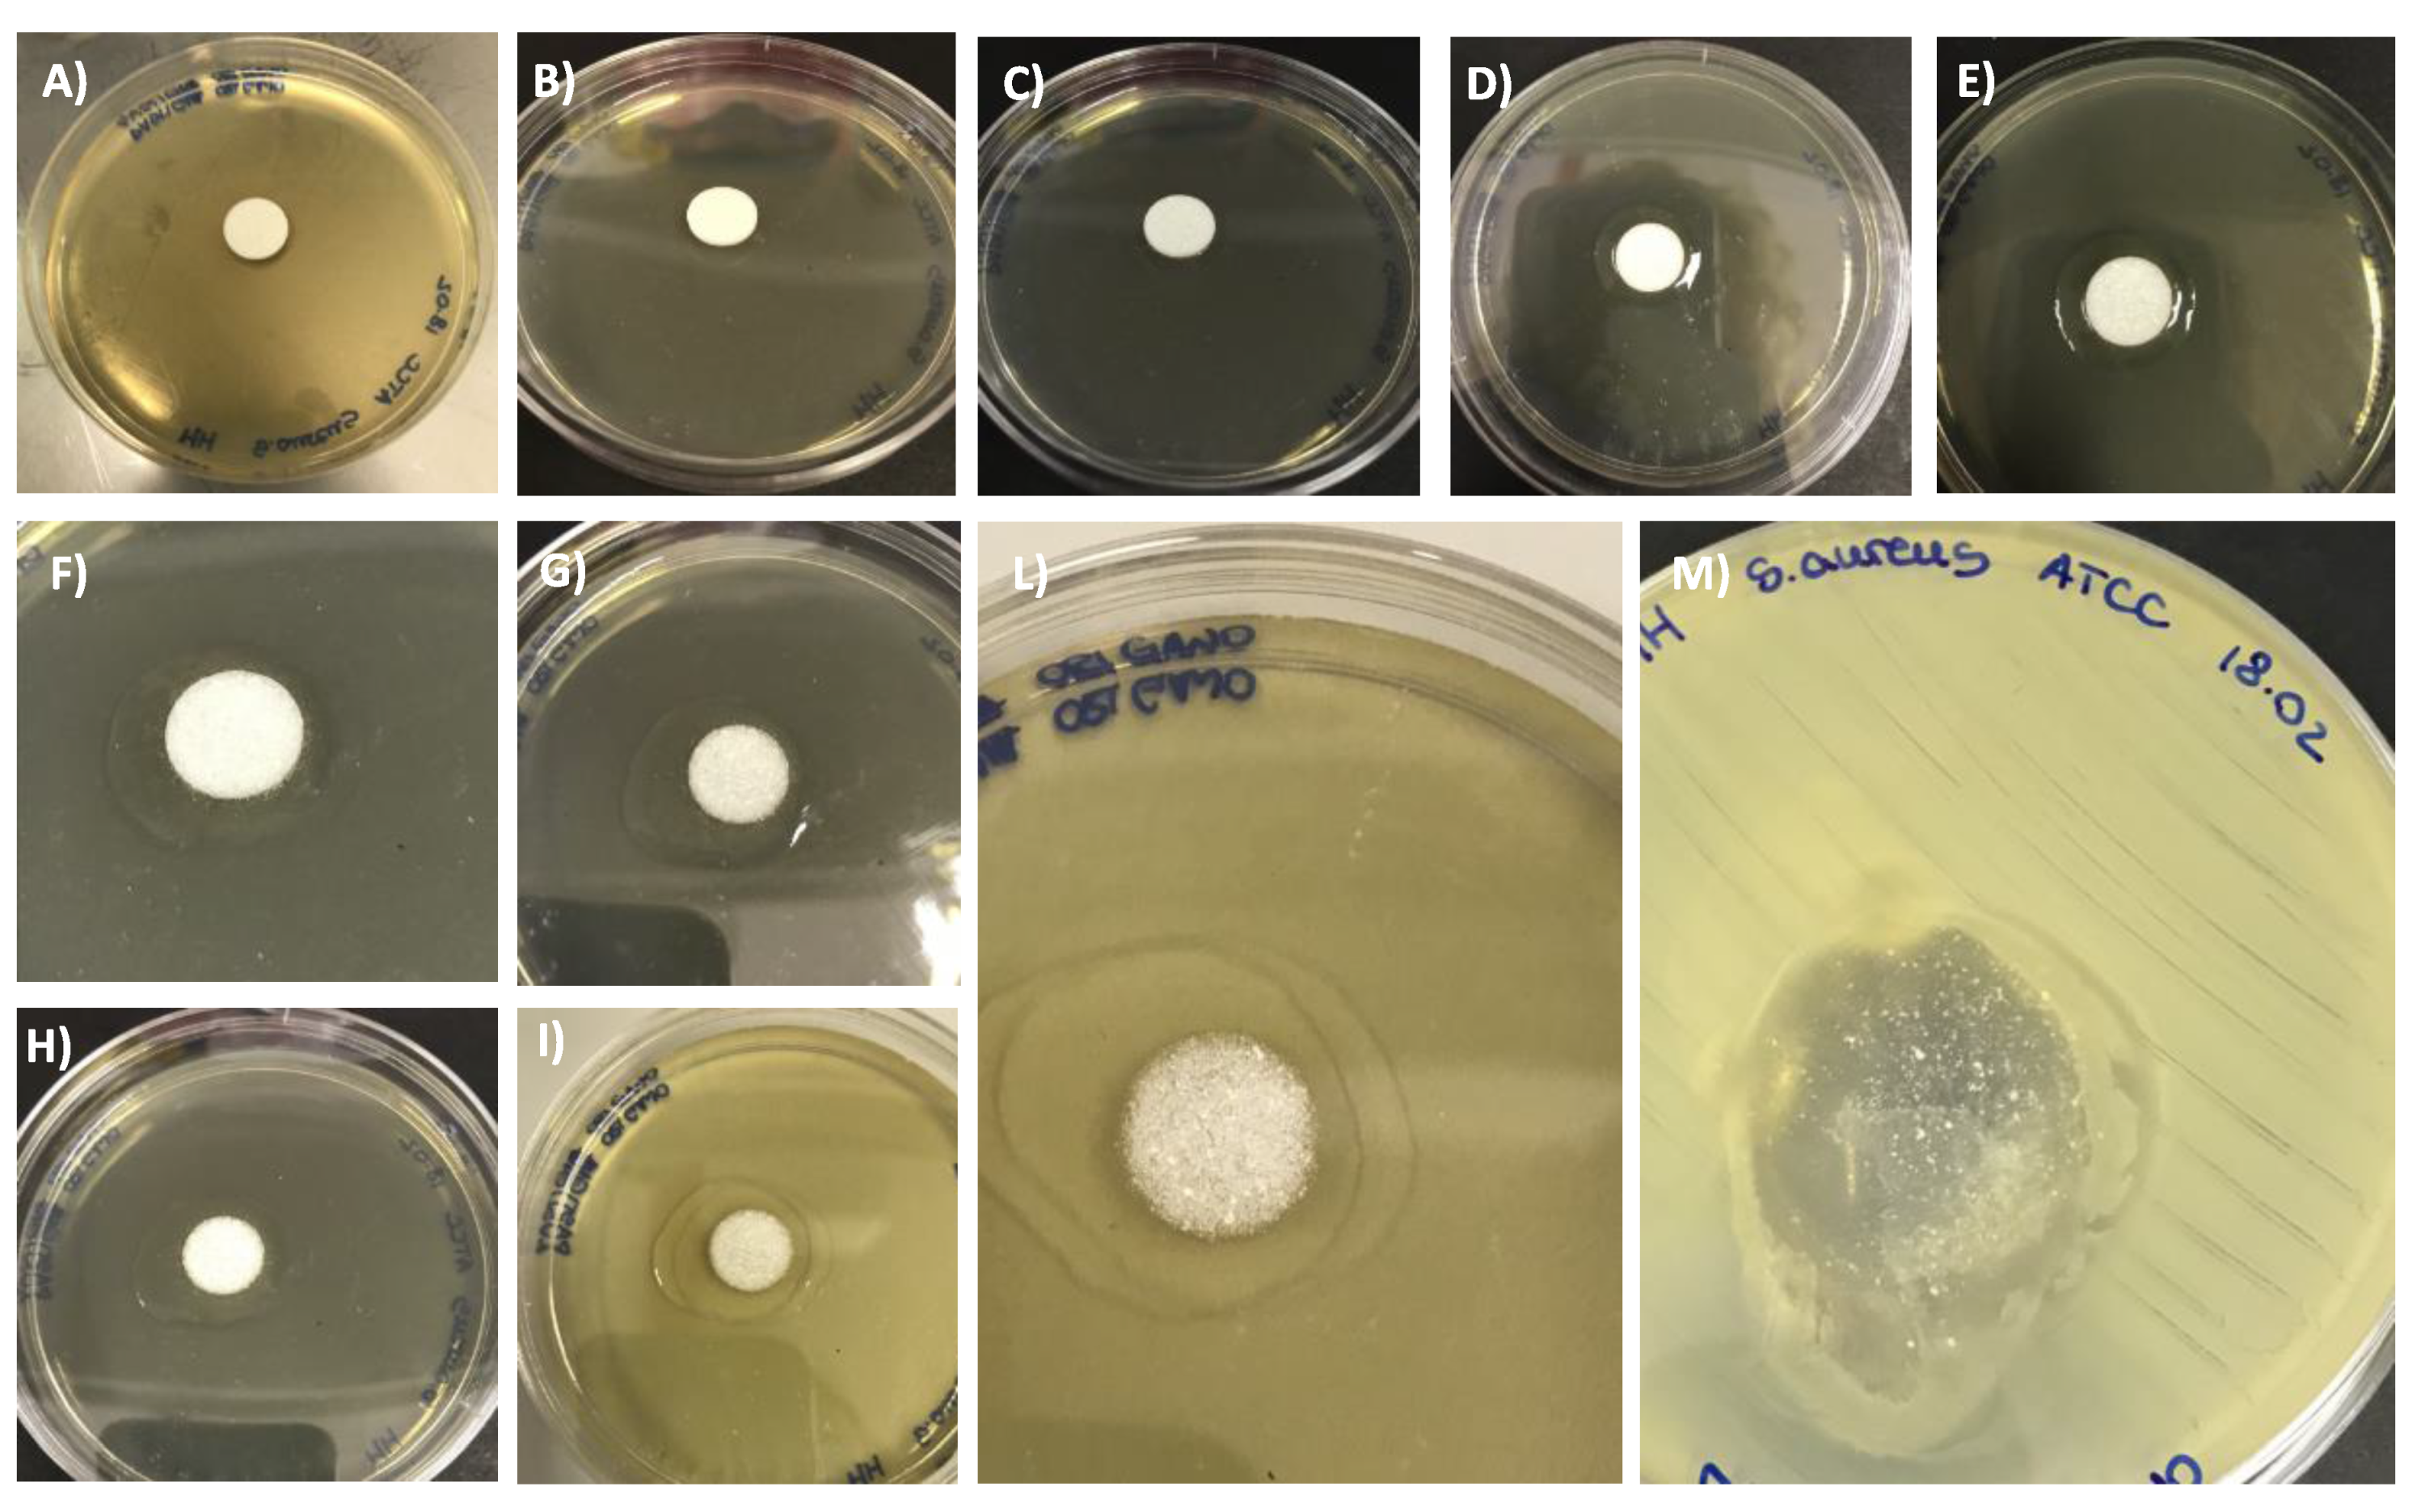

Host–Guest Inclusion Complexes of Essential Oils with Strong Antibacterial and Antifungal Features in Beta-Cyclodextrin for Solid-State Pharmaceutical Applications
Abstract
:1. Introduction
2. Materials and Methods
2.1. Synthesis of Host–Guest Molecular Inclusion Complexes
2.2. FT-IR Spectroscopy
2.3. ESI-MS Spectrometry
2.4. GC-MS Analysis
2.5. Synthesis of the Pharmaceutical b-CD–EO Tablet
2.6. Antifungal and Antibacterial Assays
2.6.1. Antifungal Assay
2.6.2. Antibacterial Assay
2.6.3. Statistical Analysis
3. Results and Discussion
3.1. Material Preparation
3.2. FT-IR Spectroscopy
3.3. Chromatographic and Mass Spectrometric Characterization
3.4. Synthesis of the Pharmaceutical b-CD–EO Tablet
3.5. Antifungal and Antibacterial Assays
4. Conclusions
Author Contributions
Funding
Institutional Review Board Statement
Informed Consent Statement
Acknowledgments
Conflicts of Interest
References
- Adalja, A.A.; Watson, M.; Toner, E.S.; Cicero, A.; Inglesby, T.V. Characteristics of Microbes Most Likely to Cause Pandemics and Global Catastrophes. In Global Catastrophic Biological Risks; Inglesby, T.V., Adalja, A.A., Eds.; Springer International Publishing: Cham, Switzerland, 2019; Volume 424, pp. 1–20. ISBN 978-3-030-36310-9. [Google Scholar]
- Sofi, M.S.; Hamid, A.; Bhat, S.U. SARS-CoV-2: A critical review of its history, pathogenesis, transmission, diagnosis and treatment. Biosaf. Health 2020, 2, 217–225. [Google Scholar] [CrossRef] [PubMed]
- World Health Organization (Ed.) Health21: The Health for All Policy Framework for the WHO European Region; European health for all series; World Health Organization, Regional Office for Europe: Copenhagen, Denmark, 1999; ISBN 978-92-890-1349-9. [Google Scholar]
- Atanasov, A.G.; Zotchev, S.B.; Dirsch, V.M.; Supuran, C.T. Natural products in drug discovery: Advances and opportunities. Nat. Rev. Drug Discov. 2021, 20, 200–216. [Google Scholar] [CrossRef] [PubMed]
- Lahlou, M. The Success of Natural Products in Drug Discovery. Pharmacol. Pharm. 2013, 04, 17–31. [Google Scholar] [CrossRef] [Green Version]
- Shabbir, M.A.B.; Shabbir, M.Z.; Wu, Q.; Mahmood, S.; Sajid, A.; Maan, M.K.; Ahmed, S.; Naveed, U.; Hao, H.; Yuan, Z. CRISPR-cas system: Biological function in microbes and its use to treat antimicrobial resistant pathogens. Ann. Clin. Microbio. Antimicrob. 2019, 18, 21. [Google Scholar] [CrossRef] [PubMed]
- Kummerer, K. Significance of antibiotics in the environment. J. Antimicrob. Chemother. 2003, 52, 5–7. [Google Scholar] [CrossRef] [PubMed] [Green Version]
- Wright, G.D. The antibiotic resistome: The nexus of chemical and genetic diversity. Nat. Rev. Microbiol. 2007, 5, 175–186. [Google Scholar] [CrossRef] [PubMed]
- World Health Organization (Ed.) Antimicrobial Resistance: Global Report on Surveillance; World Health Organization: Geneva, Switzerland, 2014; ISBN 978-92-4-156474-8. [Google Scholar]
- Alekshun, M.N.; Levy, S.B. Molecular Mechanisms of Antibacterial Multidrug Resistance. Cell 2007, 128, 1037–1050. [Google Scholar] [CrossRef] [PubMed] [Green Version]
- Erickson, K.E.; Otoupal, P.B.; Chatterjee, A. Transcriptome-Level Signatures in Gene Expression and Gene Expression Variability during Bacterial Adaptive Evolution. mSphere 2017, 2. [Google Scholar] [CrossRef] [PubMed] [Green Version]
- Antinori, S.; Milazzo, L.; Sollima, S.; Galli, M.; Corbellino, M. Candidemia and invasive candidiasis in adults: A narrative review. Eur. J. Intern. Med. 2016, 34, 21–28. [Google Scholar] [CrossRef] [PubMed]
- Adorjan, B.; Buchbauer, G. Biological properties of essential oils: An updated review. Flavour Fragr. J. 2010, 25, 407–426. [Google Scholar] [CrossRef]
- Bakkali, F.; Averbeck, S.; Averbeck, D.; Idaomar, M. Biological effects of essential oils—A review. Food Chem. Toxicol. 2008, 46, 446–475. [Google Scholar] [CrossRef] [PubMed]
- Raut, J.S.; Karuppayil, S.M. A status review on the medicinal properties of essential oils. Ind. Crops Prod. 2014, 62, 250–264. [Google Scholar] [CrossRef]
- Bona, E.; Massa, N.; Novello, G.; Pavan, M.; Rocchetti, A.; Berta, G.; Gamalero, E. Essential oil antibacterial activity against methicillin-resistant and -susceptible Staphylococcus aureus strains. Microbiol. Res. (Pavia) 2019, 10. [Google Scholar] [CrossRef] [Green Version]
- Bona, E.; Cantamessa, S.; Pavan, M.; Novello, G.; Massa, N.; Rocchetti, A.; Berta, G.; Gamalero, E. Sensitivity of Candida albicans to essential oils: Are they an alternative to antifungal agents? J. Appl. Microbiol. 2016, 121, 1530–1545. [Google Scholar] [CrossRef] [PubMed]
- Massa, N.; Cantamessa, S.; Novello, G.; Ranzato, E.; Martinotti, S.; Pavan, M.; Rocchetti, A.; Berta, G.; Gamalero, E.; Bona, E. Antifungal activity of essential oils against azole-resistant and azole-susceptible vaginal Candida glabrata strains. Can. J. Microbiol. 2018, 64, 647–663. [Google Scholar] [CrossRef]
- Bona, E.; Arrais, A.; Gema, L.; Perotti, V.; Birti, B.; Massa, N.; Novello, G.; Gamalero, E. Chemical composition and antimycotic activity of six essential oils (cumin, fennel, manuka, sweet orange, cedar and juniper) against different Candida spp. Nat. Prod. Res. 2019, 1–6. [Google Scholar] [CrossRef]
- Clericuzio, M.; Hussain, F.H.S.; Amin, H.I.M.; Bona, E.; Gamalero, E.; Giorgia, N.; Lappano, R.; Talia, M.; Maggiolini, M.; Bazzicalupo, M.; et al. Cytotoxic, Anti-bacterial, and Wound-healing Activity of Prenylated Phenols from the Kurdish Traditional Medicinal Plant Onobrychis Carduchorum (Fabaceae). Planta Medica. Int. Open 2020, 07, e106–e113. [Google Scholar] [CrossRef]
- R Core. R: A Language and Environment for Statistical Computing; R foundation for statistical computing: Vienna, Austria, 2018. [Google Scholar]
- Parlati, S.; Gobetto, R.; Barolo, C.; Arrais, A.; Buscaino, R.; Medana, C.; Savarino, P. Preparation and application of a β-cyclodextrin-disperse/reactive dye complex. J. Incl. Phenom. Macrocycl. Chem. 2007, 57, 463–470. [Google Scholar] [CrossRef]
- Arrais, A.; Savarino, P. Raman spectroscopy is a convenient technique for the efficient evaluation of cyclodextrin inclusion molecular complexes of azo-dye colorants and largely polarisable guest molecules. J. Incl. Phenom. Macrocycl. Chem. 2009, 64, 73–81. [Google Scholar] [CrossRef]

| Molecules | CAS Number | Trit | S. Montana EO | S. Montana EO + b-CD | Effects |
|---|---|---|---|---|---|
| Carvacrol | 499-75-2 | 12.43 | X | X | Antibacterial |
| 1-Hydroxy-4-methyl- 2,6-di-tert-butyl benzene (BHT) | 128-37-0 | 16.1 | X | X | Antioxidant |
| Caryophyllene oxide | 1139-30-6 | 18.27 | X | X | Relaxant effects, analgesic, tumor-suppressing agent |
| Decalin, 1-methoxymethyl | 4645-15-2 | 24.66 | X | X | |
| Heneicosane | 629-94-7 | 30.36 | X | X | EOs constituent |
| 1-Octadecanol | 112-92-5 | 30.5 | X | X | |
| Tricosane | 638-67-5 | 33.06 | X | X | |
| 9-Octadecenamide (oleamide) | 301-02-0 | 39.73 | X | X | EOs constituent |
| Molecules | CAS Number | Trit | T. Capitatus EO | EO + b-CD | Effects |
|---|---|---|---|---|---|
| Thymol | 89-83-8 | 11.20 | X | X | Antibacterial and antifungal |
| Carvacrol | 499-75-2 | 12.43 | X | X | antibacterial |
| Isoascaridole | 512-85-6 | 12.47 | X | X | |
| 1-1-Hydroxy-4-methyl-2,6-di-tert-butyl benzene (BHT) | 128-37-0 | 16.1 | X | X | Antioxidant |
| Caryophyllene oxide | 1139-30-6 | 18.27 | X | X | Relaxant effects, analgesic, tumor suppressing agent |
| Heptadecanitrile | 5399-02-0 | 24.82 | X | X | |
| Oleanitrile | 112-91-4 | 28.20 | X | X | Plant Metabolite |
| Tricosane | 638-67-5 | 32.08 | X | X | |
| 9-Octadecenamide (oleamide) | 301-02-0 | 33.07 | X | X | Cannabinoid mimic |
Publisher’s Note: MDPI stays neutral with regard to jurisdictional claims in published maps and institutional affiliations. |
© 2021 by the authors. Licensee MDPI, Basel, Switzerland. This article is an open access article distributed under the terms and conditions of the Creative Commons Attribution (CC BY) license (https://creativecommons.org/licenses/by/4.0/).
Share and Cite
Arrais, A.; Manzoni, M.; Cattaneo, A.; Gianotti, V.; Massa, N.; Novello, G.; Caramaschi, A.; Gamalero, E.; Bona, E. Host–Guest Inclusion Complexes of Essential Oils with Strong Antibacterial and Antifungal Features in Beta-Cyclodextrin for Solid-State Pharmaceutical Applications. Appl. Sci. 2021, 11, 6597. https://doi.org/10.3390/app11146597
Arrais A, Manzoni M, Cattaneo A, Gianotti V, Massa N, Novello G, Caramaschi A, Gamalero E, Bona E. Host–Guest Inclusion Complexes of Essential Oils with Strong Antibacterial and Antifungal Features in Beta-Cyclodextrin for Solid-State Pharmaceutical Applications. Applied Sciences. 2021; 11(14):6597. https://doi.org/10.3390/app11146597
Chicago/Turabian StyleArrais, Aldo, Marta Manzoni, Alessia Cattaneo, Valentina Gianotti, Nadia Massa, Giorgia Novello, Alice Caramaschi, Elisa Gamalero, and Elisa Bona. 2021. "Host–Guest Inclusion Complexes of Essential Oils with Strong Antibacterial and Antifungal Features in Beta-Cyclodextrin for Solid-State Pharmaceutical Applications" Applied Sciences 11, no. 14: 6597. https://doi.org/10.3390/app11146597
APA StyleArrais, A., Manzoni, M., Cattaneo, A., Gianotti, V., Massa, N., Novello, G., Caramaschi, A., Gamalero, E., & Bona, E. (2021). Host–Guest Inclusion Complexes of Essential Oils with Strong Antibacterial and Antifungal Features in Beta-Cyclodextrin for Solid-State Pharmaceutical Applications. Applied Sciences, 11(14), 6597. https://doi.org/10.3390/app11146597

